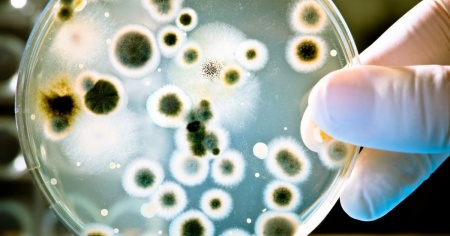

I germi che aiutano il sistema immunitario dei bambini
Lavarsi le mani è sempre l’insegnamento più utile per prevenire contagi ed infezioni
L’asilo nido e le scuole d’infanzia sono il regno dei germi, non perché siano ambienti sporchi o trascurati, bensì perché sono frequentate dai bambini piccoli che diffondono allegramente i propri germi, toccando un compagno dopo aver messo le manine in bocca o averle usate per strofinarsi gli occhi o il naso. Vero è che i germi sparsi allegramente dai pargoletti, come fossero petali di fiori a un matrimonio, sono importanti per lo sviluppo del sistema immunitario, e alcune ricerche hanno riscontrato che proprio i bimbetti che si ammalavano spesso al nido, crescendo si sono rivelati più refrattari alle malattie più serie. E la scienza continua ad approfondire questo aspetto. Certo la diffusione dei germi può essere contenuta invogliando al frequente e corretto lavaggio delle manine che, quando sono sporche, sono il principale mezzo di trasmissione dei germi: più di un colpo di tosse o uno starnuto!
Acqua e sapone, quindi, sono i principali alleati nella crociata contro i batteri e lavare le manine deve diventare un’abitudine da praticare spesso e volentieri e, soprattutto, dopo essere andati in bagno, dopo aver tossito e starnutito, dopo aver giocato, dopo aver accarezzato un animale e prima di mangiare. L’utilizzo dei fazzolettini di carta è utile per sostituire l’uso delle mani in caso di starnuti e tosse, con l’accortezza di gettare subito i fazzoletti usati per pulire il nasino. Buona norma sarebbe che i pargoli non condividessero stoviglie ed asciugamani con altre persone, soprattutto quando sono malati. Mentre per tutto il resto le norme di igiene quotidiana sono sempre valide ed utili, ricordando che i bambini non hanno bisogno di vivere in ambienti asettici perché altrimenti non sviluppano il sistema immunitario, ma hanno bisogno di conoscere le norme igieniche e di vederle applicate anche dagli adulti.






Su alcuni temi riceviamo purtroppo con frequenza messaggi contenenti insulti e incitamento all'odio e, nonostante i nostri sforzi, non riusciamo a garantire un dialogo costruttivo. Per le stesse ragioni, disattiviamo i commenti anche negli articoli dedicati a decessi, crimini, processi e incidenti.
Il confronto con i nostri lettori rimane per noi fondamentale: è una parte centrale della nostra piattaforma. Per questo ci impegniamo a mantenere aperta la discussione ogni volta che è possibile.
Dipende anche da voi: con interventi rispettosi, costruttivi e cortesi, potete contribuire a mantenere un dialogo aperto, civile e utile per tutti. Non vediamo l'ora di ritrovarvi nella prossima sezione commenti!